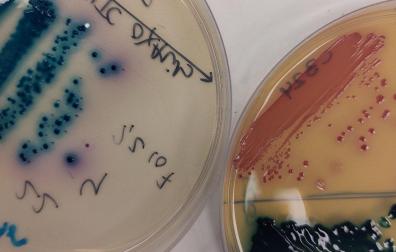
Placas de petri con cultivos de bacterias resistentes a antibióticos aisladas de pacientes. En azul puede observarse a ‘Klebsiella pneumoniae’, y en rojo, a ‘Escherichia coli’

Salud
Talidomida: qué es y cuándo llega a España el nuevo medicamento contra el cáncer
Su comercialización se iniciará el próximo 2 de febrero


Publicado el 16/01/2023 a las 10:31
Un nuevo fármaco llega a España para combatir ciertos tipos de cáncer. Según anuncia en un comunicado la Agencia Española de Medicamentos y Productos Sanitarios (AEMPS), bajo el paraguas del Ministerio de Sanidad, el próximo 2 de febrero se comercializará talidomida en el país. Se trata de un medicamento, el Talidomida Accord 50 mg cápsulas duras EFG, que se venderá por primera vez en España, señala este organismo.
Su única indicación autorizada, en combinación con melfalán y prednisona, se fija para el tratamiento de primera línea en pacientes con mieloma múltiple no tratado, de edad igual o mayor de 65 años o no aptos para recibir quimioterapia a altas dosis, siendo un medicamento de dispensación en hospitales.
Este organismo informa en su página web que “debido al riesgo de producir malformaciones congénitas graves, en la Unión Europea se han establecido una serie de requisitos para su prescripción y dispensación con un Plan de Prevención de Embarazos (PPE) y un Sistema de Acceso Controlado cuyo objetivo es evitar cualquier exposición a talidomida en mujeres embarazadas. Estos requisitos serán de aplicación para cualquier medicamento comercializado que contenga este principio activo”, recoge el comunicado de su portal online sobre sus efectos en la salud.
Así, AEMPS apunta una serie de requisitos para cumplir las condiciones establecidas en el Programa de Prevención de Embarazos. "Las mujeres con capacidad de gestación solo podrán tratarse si se cumple lo siguiente: Utilización de medidas anticonceptivas eficaces sin interrupción según lo estipulado en la ficha técnica; Realización de pruebas de embarazo antes de iniciar el tratamiento, cada cuatro semanas durante el tratamiento y cuatro semanas después de finalizar el mismo; Comprensión acerca del riesgo de malformaciones congénitas graves para el feto en caso de embarazo, sobre otros riesgos graves del tratamiento y la necesidad de consultar rápidamente a su médico si piensa que puede estar embarazada", señala.
También pone el foco en los hombres. “En pacientes varones, se informará de la posibilidad de riesgo de malformaciones congénitas graves si mantiene relaciones sexuales con una mujer embarazada o con posibilidades de estarlo, al excretarse talidomida a través del semen, por lo que es necesario usar preservativo durante todo el tratamiento (incluyendo en periodos de interrupción de la administración) y durante al menos siete días después de finalizarlo”, indica AEMPS.
MÁS NOTICIAS:
El CIMA participa en un proyecto que plantea un cambio de paradigma en la lucha contra el cáncer